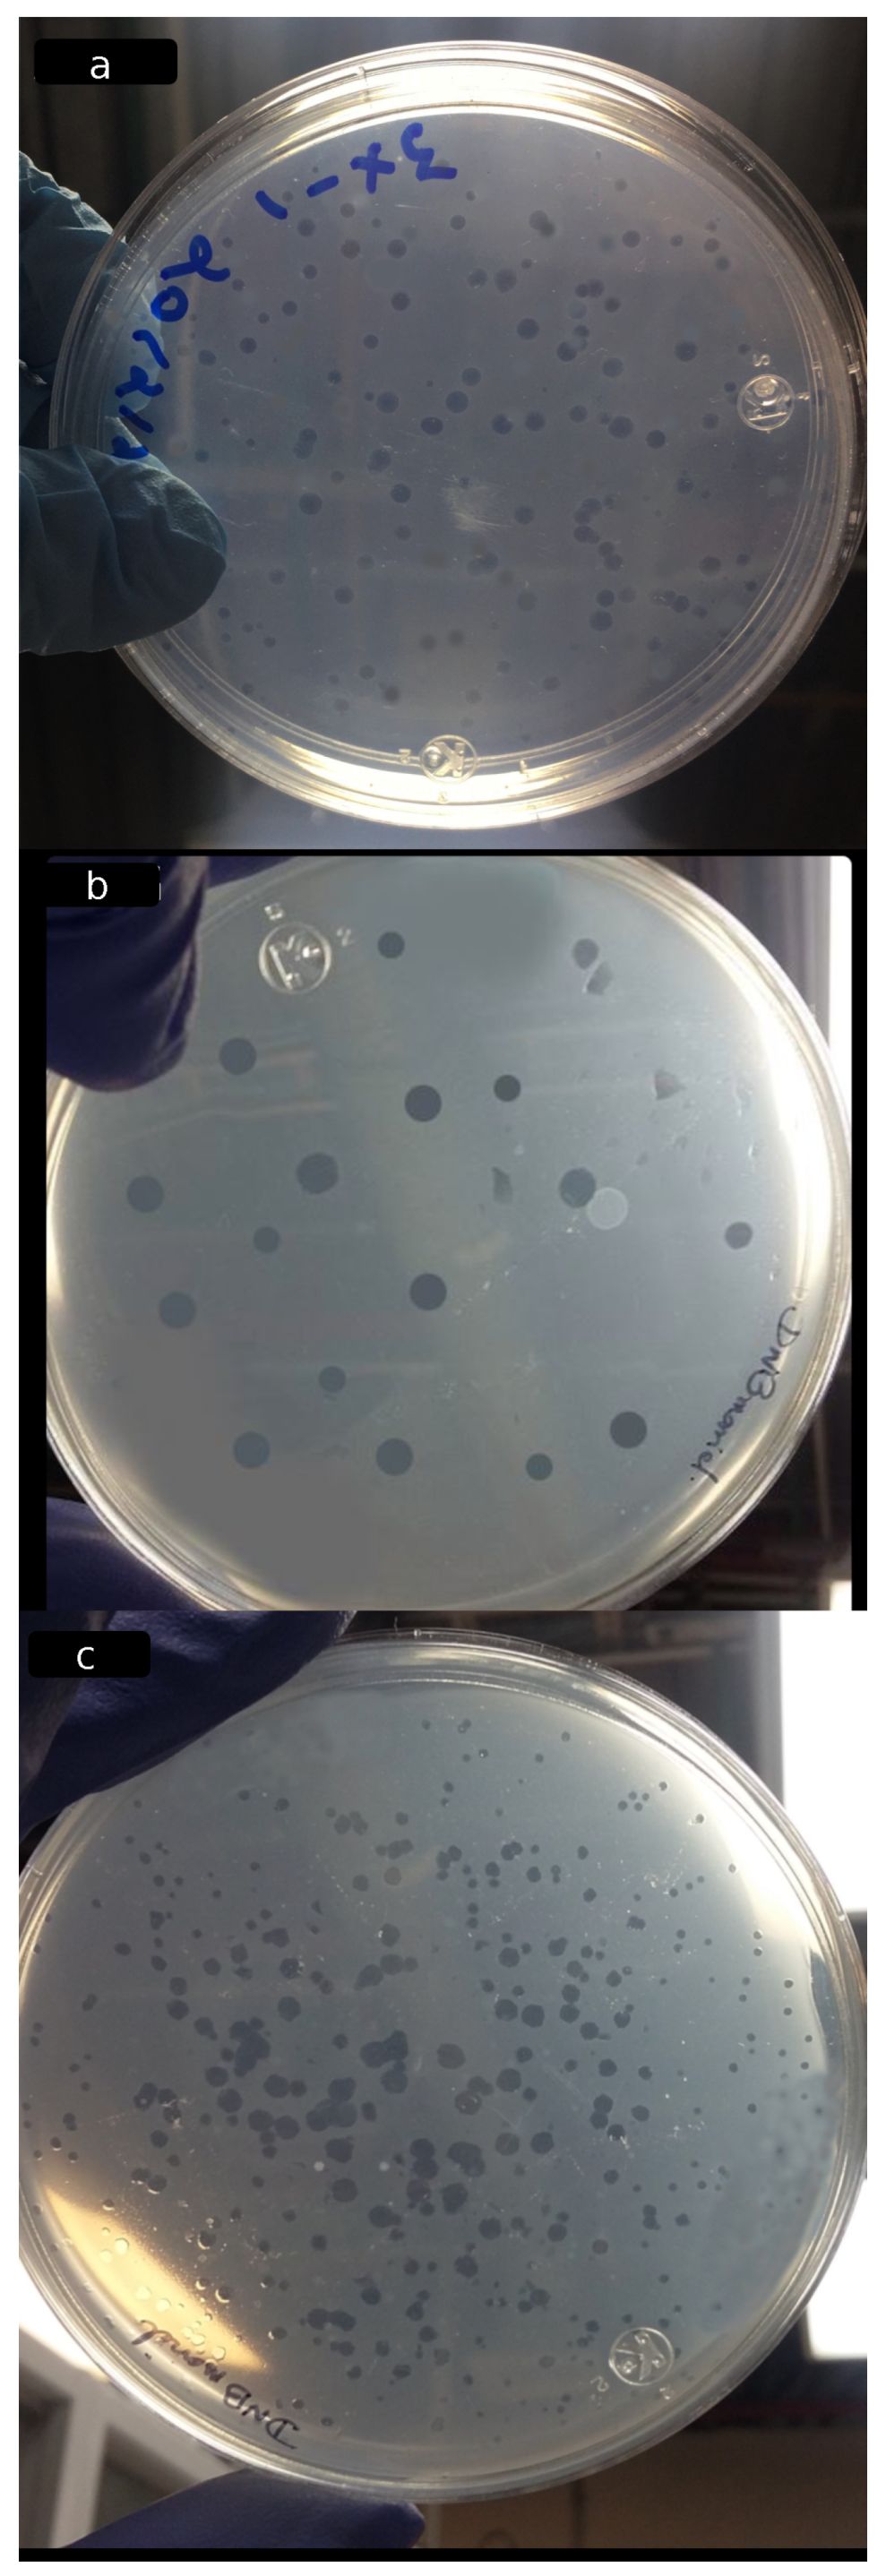
Coatings 11 00605 g007 Coatings 11 00605 g007

Active Biopolymeric Films Inoculated with Bdellovibrio bacteriovorus, a Predatory Bacterium
Abstract
1. Introduction
2. Materials and Methods
2.1. Biopolymers, Media, and Bacterial Strains
2.2. Inoculum Preparation
2.3. B. bacteriovorus Entrapment in Biopolymeric Films
2.3.1. Scanning Electron Microscopy (SEM)
2.3.2. Evaluation of the Entrapment Yield of B. bacteriovorus in the Biopolymeric Films
2.3.3. Lytic Activity of B. bacteriovorus HD100 against E. coli DH5 in Co-Culture Assay
2.4. Physicochemical Properties of Biofilms
2.4.1. Fourier Transform Infrared Spectroscopy (FTIR)
2.4.2. X-ray Diffraction (XRD) Analysis of the Biopolymeric Films
2.4.3. Thermal Analysis by Differential Scanning Calorimetry (DSC)
2.4.4. Mechanical Analysis of the Biopolymeric Films
3. Results and Discussion
3.1. Molecular Interactions
3.2. Thermal Analysis by DSC
3.3. XRD Analysis
3.4. Mechanical Properties
3.5. Visualization of Bdellovibrio bacteriovorus HD100 Strain by SEM
3.6. Viability of B. bacteriovorus HD100 in the Biofilms
4. Conclusions
Author Contributions
Funding
Institutional Review Board Statement
Informed Consent Statement
Data Availability Statement
Acknowledgments
Conflicts of Interest
Abbreviations
| CA-S | collagen-sodium alginate film plasticized with sorbitol |
| CA-G | collagen-sodium alginate film plasticized with glycerol |
| StA-G | tapioca starch–sodium alginate film plasticized with glycerol |
| entrapment yield |
References
- Kumar, S.; Mukherjee, A.; Dutta, J. Chitosan Based Nanocomposite Films and Coatings: Emerging Antimicrobial Food Packaging Alternatives. Trends Food Sci. Technol. 2020, 97, 196–209. [Google Scholar] [CrossRef]
- Li, C.; Pei, J.; Xiong, X.; Xue, F. Encapsulation of Grapefruit Essential Oil in Emulsion-Based Edible Film Prepared by Plum (Pruni Domesticae Semen) Seed Protein Isolate and Gum Acacia Conjugates. Coatings 2020, 10, 784. [Google Scholar] [CrossRef]
- Morales, P.; Aguirre, J.; Troncoso, M.; Figueroa, G. Comparison of in Vitro and in Situ Antagonism Assays as Tools for the Selection of Bio-Preservative Lactic Acid Bacteria (LAB) in Poultry Meat. LWT 2020, 118, 108846. [Google Scholar] [CrossRef]
- Shaikh, S.M.; Doijad, R.C.; Shete, A.S.; Sankpal, P.S. A Review on: Preservatives used in Pharmaceuticals and impacts on Health. Pharma Tutor 2016, 4, 25–34. [Google Scholar]
- Thomashow, M.F.; Cotter, T.W. Bdellovibrio Host Dependence: The Search for Signal Molecules and Genes that Regulate the Intraperiplasmic Growth Cycle. J. Bacteriol. 1992, 174, 5767. [Google Scholar] [CrossRef] [PubMed][Green Version]
- Engelking, H.M.; Seidler, R.J. The Involvement of Extracellular Enzymes in the Metabolism ofBdellovibrio. Arch. Microbiol. 1974, 95, 293–304. [Google Scholar] [CrossRef] [PubMed]
- Iebba, V.; Santangelo, F.; Totino, V.; Nicoletti, M.; Gagliardi, A.; De Biase, R.V. Higher Prevalence and Abundance of Bdellovibrio bacteriovorus in the Human Gut of Healthy Subjects. PLoS ONE 2013, 8, e61608. [Google Scholar] [CrossRef]
- Bonfiglio, G.; Neroni, B.; Radocchia, G.; Marazzato, M.; Pantanella, F.; Schippa, S. Insight into the Possible Use of the Predator Bdellovibrio bacteriovorus as a Probiotic. Nutrients 2020, 12, 2252. [Google Scholar] [CrossRef]
- Hong, H.; Fan, H.; Chalamaiah, M.; Wu, J. Preparation of Low-Molecular-Weight, Collagen Hydrolysates (Peptides): Current Progress, Challenges, and Future Perspectives. Food Chem. 2019, 301, 125222. [Google Scholar] [CrossRef] [PubMed]
- Shi, D.; Liu, F.; Yu, Z.; Chang, B.; Goff, H.D.; Zhong, F. Effect of Aging Treatment on the Physicochemical Properties of Collagen Films. Food Hydrocoll. 2019, 87, 436–447. [Google Scholar] [CrossRef]
- Chen, X.; Zhou, L.; Xu, H.; Yamamoto, M.; Shinoda, M.; Tada, I.; Minami, S.; Urayama, K.; Yamane, H. The Structure and Properties of Natural Sheep Casing and Artificial Films Prepared from Natural Collagen with various Crosslinking Treatments. Int. J. Biol. Macromol. 2019, 135, 959–968. [Google Scholar] [CrossRef]
- Bhuimbar, M.V.; Bhagwat, P.K.; Dandge, P.B. Extraction and Characterization of Acid Soluble Collagen from Fish Waste: Development of Collagen-Chitosan Blend as Food Packaging Film. J. Environ. Chem. Eng. 2019, 7, 102983. [Google Scholar] [CrossRef]
- Wang, Z.; Hu, S.; Wang, H. Scale-Up Preparation and Characterization of Collagen/Sodium Alginate Blend Films. J. Food Qual. 2017, 2017, 4954259. [Google Scholar] [CrossRef]
- Santacruz, S.; Castro, M. Viability of Free and Encapsulated Lactobacillus Acidophilus Incorporated to Cassava Starch Edible Films and its Application to Manaba Fresh White Cheese. LWT 2018, 93, 570–572. [Google Scholar] [CrossRef]
- Oyedara, O.O.; De Luna-Santillana, E.J.; Olguin-Rodriguez, O.; Guo, X.; Mendoza-Villa, M.; Menchaca-Arredondo, J.; Elufisan, T.O.; Garza-Hernandez, J.; Garcia Leon, I.; Rodriguez-Perez, M. Isolation of Bdellovibrio Sp. from Soil Samples in Mexico and their Potential Applications in Control of Pathogens. Microbiologyopen 2016, 5, 992–1002. [Google Scholar] [CrossRef] [PubMed]
- Dong, H.; Hou, H.; Liu, C.; Zhang, H. Relationships between some Physicochemical Properties of Starches from Maize Cultivars Grown in East China. Starch-Stärke 2008, 60, 305–314. [Google Scholar] [CrossRef]
- García-Tejeda, Y.V.; Leal-Castañeda, E.J.; Espinosa-Solis, V.; Barrera-Figueroa, V. Synthesis and Characterization of Rice Starch Laurate as Food-Grade Emulsifier for Canola Oil-in-Water Emulsions. Carbohydr. Polym. 2018, 194, 177–183. [Google Scholar] [CrossRef]
- Romero-Bastida, C.A.; Bello-Pérez, L.A.; Velazquez, G.; Alvarez-Ramirez, J. Effect of the Addition Order and Amylose Content on Mechanical, Barrier and Structural Properties of Films made with Starch and Montmorillonite. Carbohydr. Polym. 2015, 127, 195–201. [Google Scholar] [CrossRef] [PubMed]
- García-Tejeda, Y.V.; Salinas-Moreno, Y.; Hernández-Martínez, Á.R.; Martínez-Bustos, F. Encapsulation of Purple Maize Anthocyanins in Phosphorylated Starch by Spray Drying. Cereal Chem. 2016, 93, 130–137. [Google Scholar] [CrossRef]
- Fazaeli, M.; Emam-Djomeh, Z.; Kalbasi Ashtari, A.; Omid, M. Effect of Spray Drying Conditions and Feed Composition on the Physical Properties of Black Mulberry Juice Powder. Food Bioprod. Process. 2012, 90, 667–675. [Google Scholar] [CrossRef]
- Siddaramaiah; Swamy, T.M.M.; Ramaraj, B.; Lee, J.H. Sodium Alginate and its Blends with Starch: Thermal and Morphological Properties. J. Appl. Polym. Sci. 2008, 109, 4075–4081. [Google Scholar] [CrossRef]
- Wang, L.; Wang, Y. Structures and Physicochemical Properties of Acid-Thinned Corn, Potato and Rice Starches. Starch-Stärke 2001, 53, 570–576. [Google Scholar] [CrossRef]
- Pereira, R.; Tojeira, A.; Vaz, D.C.; Mendes, A.; Bártolo, P. Preparation and characterization of films based on alginate and aloe vera. Int. J. Polym. Anal. Charact. 2011, 16, 449–464. [Google Scholar] [CrossRef]
- Rizk, M.A.; Mostafa, N.Y. Extraction and Characterization of Collagen from Buffalo Skin for Biomedical Applications. Orient. J. Chem. 2016, 32, 1601–1609. [Google Scholar] [CrossRef]
- Liao, W.; Guanghua, X.; Li, Y.; Shen, X.R.; Li, C. Comparison of Characteristics and Fibril-Forming Ability of Skin Collagen from Barramundi (Lates Calcarifer) and Tilapia (Oreochromis Niloticus). Int. J. Biol. Macromol. 2018, 107, 549–559. [Google Scholar] [CrossRef]
- Abdel Aziz, M.S.; Salama, H.E.; Sabaa, M.W. Biobased alginate/castor Oil Edible Films for Active Food Packaging. LWT 2018, 96, 455–460. [Google Scholar] [CrossRef]
- Zhang, R.; Wang, W.; Zhang, H.; Dai, Y.; Dong, H.; Hou, H. Effects of Hydrophobic Agents on the Physicochemical Properties of Edible agar/maltodextrin Films. Food Hydrocoll. 2019, 88, 283–290. [Google Scholar] [CrossRef]
- Elango, J.; Bu, Y.; Bin, B.; Geevaretnam, J.; Robinson, J.S.; Wu, W. Effect of Chemical and Biological Cross-Linkers on Mechanical and Functional Properties of Shark Catfish Skin Collagen Films. Food Biosci. 2017, 17, 42–51. [Google Scholar] [CrossRef]
- Xie, Z.; He, M.; Zhai, Y.; Xin, F.; Yu, S.; Zhao, H.; Xiao, H.; Song, Y. Preparation of Collagen Casings with High Mechanical Properties using Response Surface Methodology. Am. J. Biochem. Biotechnol. 2021, 17, 1–15. [Google Scholar] [CrossRef]
- Otàlora Gonzàlez, C.M.; Flores, S.K.; Basanta, M.F.; Gerschenson, L.N. Effect of Beetroot (Beta Vulgaris L. Var Conditiva) Fiber Filler and Corona Treatment on Cassava Starch Films Properties. Food Packag. Shelf Life 2020, 26, 100605. [Google Scholar] [CrossRef]
- Markovicová, L.; Zatkalíková, V.; Kojnoková, T.; Gana, D.; Liptáková, T. The physical - mechanical properties of low-density polyethylene films. IOP Conf. Ser. Mater. Sci. Eng. 2020, 726, 012008. [Google Scholar] [CrossRef]
- Nurul Syahida, S.; Ismail-Fitry, M.R.; Ainun, Z.M.A.; Nur Hanani, Z.A. Effects of gelatin/palm wax/lemongrass Essential Oil (GPL)-Coated Kraft Paper on the Quality and Shelf Life of Ground Beef Stored at 4 ∘C. Food Packag. Shelf Life 2021, 28, 100640. [Google Scholar] [CrossRef]
- Zhang, H.; Peng, M.; Cheng, T.; Zhao, P.; Qiu, L.; Zhou, J.; Lu, G.; Chen, J. Silver Nanoparticles-Doped collagen–alginate Antimicrobial Biocomposite as Potential Wound Dressing. J. Mater. Sci. 2018, 53, 14944–14952. [Google Scholar] [CrossRef]
- Zarate-Triviño, D.G.; Pool, H.; Vergara-Castañeda, H.; Elizalde-Peña, E.A.; Vallejo-Becerra, V.; Villaseñor, F.; Prokhorov, E.; Gough, J.; Garcia-Gaitan, B.; Luna-Barcenas, G. (Chitosan-g-Glycidyl Methacrylate)-Collagen II Scaffold for Cartilage Regeneration. Int. J. Polym. Mater. Polym. Biomater. 2020, 69, 1043–1053. [Google Scholar] [CrossRef]
- Lee, H.; Ahn, S.; Kim, G.H. Three-Dimensional Collagen/Alginate Hybrid Scaffolds Functionalized with a Drug Delivery System (DDS) for Bone Tissue Regeneration. Chem. Mater. 2012, 24, 881–891. [Google Scholar] [CrossRef]
- Núñez, M.E.; Martin, M.O.; Duong, L.K.; Ly, E.; Spain, E.M. Investigations into the Life Cycle of the Bacterial Predator Bdellovibrio Bacteriovorus 109J at an Interface by Atomic Force Microscopy. Biophys. J. 2003, 84, 3379–3388. [Google Scholar] [CrossRef][Green Version]
- Siadat, S.M.; Silverman, A.A.; DiMarzio, C.A.; Ruberti, J.W. Measuring Collagen Fibril Diameter with Differential Interference Contrast Microscopy. J. Struct. Biol. 2021, 213, 107697. [Google Scholar] [CrossRef]
- Stolp, H.; Starr, M.P. Bdellovibrio Bacteriovorus Gen. Et Sp. n., a Predatory, Ectoparasitic, and Bacteriolytic Microorganism. Antonie Leeuwenhoek 1963, 29, 217–248. [Google Scholar] [CrossRef]
- Dashiff, A.; Kadouri, D.E. Predation of Oral Pathogens by Bdellovibrio Bacteriovorus 109J. Mol. Oral Microbiol. 2011, 26, 19–34. [Google Scholar] [CrossRef]
- Cao, H.; Wang, H.; Yu, J.; An, J.; Chen, J. Encapsulated Bdellovibrio Powder as a Potential Bio-Disinfectant Against Whiteleg Shrimp-Pathogenic Vibrios. Microorganisms 2019, 7, 244. [Google Scholar] [CrossRef]
), tapioca starch (
), hydrolyzed collagen (
).
), tapioca starch (
), hydrolyzed collagen (
).
), CA-G (
), and CA-S (
). The arrow indicates a new peak at 1078 cm in the CA-S sample.
), CA-G (
), and CA-S (
). The arrow indicates a new peak at 1078 cm in the CA-S sample.
), CA-G (
), and CA-S (
). Zooming in on a portion of the graph showing the melting point of the CA-G and CA-S films.
), CA-G (
), and CA-S (
). Zooming in on a portion of the graph showing the melting point of the CA-G and CA-S films.
), sodium alginate (
), and tapioca starch (
).
), sodium alginate (
), and tapioca starch (
).
), CA-G (
), StA-G (
). The arrow indicates a shoulder in the CA-G sample.
), CA-G (
), StA-G (
). The arrow indicates a shoulder in the CA-G sample.

| Analysis | StA-G | CA-G | CA-S |
|---|---|---|---|
| Mechanical properties: | |||
| Thickness (m) | 32.6 ± 0.03 a | 96.6 ± 0.16 b | 37.9 ± 0.17 a |
| (MPa) | 3.166 ± 0.98 a | 0.965 ± 0.15 b | 4.781 ± 0.89 a |
| E (%) | 83.25 ± 8.07 b | 73.60 ± 7.96 c | 41.07 ± 5.23 a |
| (MPa) | 0.031 ± 0.00 b | 0.021 ± 0.00 b | 0.746 ± 0.18 a |
| Viability of B. bacteriovorus in the films: | |||
| Cell density (PFU/g) | 2.8 × 10 c | 2.2 × 10 b | 3.0 × 10 a |
| (%) | 80.58 | 79.28 | 93.46 |
Publisher’s Note: MDPI stays neutral with regard to jurisdictional claims in published maps and institutional affiliations. |
© 2021 by the authors. Licensee MDPI, Basel, Switzerland. This article is an open access article distributed under the terms and conditions of the Creative Commons Attribution (CC BY) license (https://creativecommons.org/licenses/by/4.0/).
Share and Cite
Sáenz-Santos, C.M.; Opemipo Oyedara, O.; García-Tejeda, Y.V.; Romero-Bastida, C.A.; García-Oropesa, E.M.; Villalobo, E.; Rodríguez-Pérez, M.A. Active Biopolymeric Films Inoculated with Bdellovibrio bacteriovorus, a Predatory Bacterium. Coatings 2021, 11, 605. https://doi.org/10.3390/coatings11050605
Sáenz-Santos CM, Opemipo Oyedara O, García-Tejeda YV, Romero-Bastida CA, García-Oropesa EM, Villalobo E, Rodríguez-Pérez MA. Active Biopolymeric Films Inoculated with Bdellovibrio bacteriovorus, a Predatory Bacterium. Coatings. 2021; 11(5):605. https://doi.org/10.3390/coatings11050605
Chicago/Turabian StyleSáenz-Santos, Christian Mariel, Omotayo Opemipo Oyedara, Yunia Verónica García-Tejeda, Claudia A. Romero-Bastida, Esperanza Milagros García-Oropesa, Eduardo Villalobo, and Mario A. Rodríguez-Pérez. 2021. "Active Biopolymeric Films Inoculated with Bdellovibrio bacteriovorus, a Predatory Bacterium" Coatings 11, no. 5: 605. https://doi.org/10.3390/coatings11050605
APA StyleSáenz-Santos, C. M., Opemipo Oyedara, O., García-Tejeda, Y. V., Romero-Bastida, C. A., García-Oropesa, E. M., Villalobo, E., & Rodríguez-Pérez, M. A. (2021). Active Biopolymeric Films Inoculated with Bdellovibrio bacteriovorus, a Predatory Bacterium. Coatings, 11(5), 605. https://doi.org/10.3390/coatings11050605

